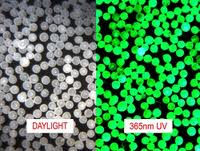

About Author:
Rajesh Mujoriya
Sardar patel college of technology,
Balaghat, dis. Balaghat,
MP–481001,INDIA
Abstract
Microspheres offer an excellent solution to creating precise pore sizes in ceramics at reasonable prices. Polyethylene microspheres offer the added benefit of minimal residue after firing, and the availability in wide size ranges from a few micron up to 1000um (1mm). Highly spherical microspheres have the added benefit of creating strong pores without any stress risers. Biodegradable microspheres are used to control drug release rates thereby decreasing toxic side effects, and eliminating the inconvenience of repeated injections. Microparticulate carrier system can be administered through different routes such as i.v,ocular,i.m,oral,intra arterial.etc.Each routes has it’s own biological significance, limitation & pharmaceutical feasibility.
WHAT IS A MICROSPHERE?
“Microspheres are defined as solid spherical particles containing dispersed drug in either solution or micro-crystalline form”.
“A plastic compound used in some dermal fillers for the correction of wrinkles that are filled with a substance and released as the shell disintegrates”
“Small, hollow glass spheres used as fillers n epoxy and polyester compounds to reduce density”
[adsense:336x280:8701650588]
Reference Id: PHARMATUTOR-ART-1157
ADVANTAGE OF MICROSPHERE
1. Controlled release delivery Biodegradable microspheres are used to control drug release rates thereby decreasing toxic side effects, and eliminating the inconvenience of repeated injections.
2. Biodegradable microspheres have the advantage over large polymer implants in that they do not require surgical procedures for implantation and removal.
3. PLGA copolymer is one of the synthetic biodegradable and biocompatible polymers that have reproducible and slow-release characteristics in vivo.
1) Type Of Microspheres :
1.1) Fluorescent Microspheres
Fluorescent Microspheres are round spherical particles that emit bright colors when illuminated by UV light. Ability to emit intense color under UV (black light) illumination provides contrast and visibility of Microspheres relative to background materials. For example, fluorescent micro beads are often used as traces to simulate spread of viruses in medical research.
Fig. 1 FLUORESCENT MICROSPHERES
Fluorescent spheres have a unique ability to appear translucent (clear) and practically invisible under ordinary light, and emit intense visible color when energized by ultraviolet (UV) light. This effect allows scientists and engineers to design blind tests and controlled experiments (e.g. simulate spread of viruses) This unique feature of fluorescent
Microspheres has numerous applications in biomedical research and process troubleshooting.
1.2) Glass Microsphere
Glass Microspheres are microscopic spheres of glass manufactured for a wide variety of uses in research, medicine, consumer goods and various industries. Glass Microspheres are usually between 1 to 1000 micrometers in diameter, although the sizes can range from 100 nanometers to 5 millimeters in diameter..
Hollow spheres are used as a light weight filler in composite materials such as syntactic foam and concrete. Hollow spheres also have uses ranging from storage and slow release of pharmaceuticals and radioactive tracers to research in controlled storage and release of hydrogen.

Fig. 2. GLASS MICROSPHERE
1.3) Paramagnetic Microsphere
They have the ability to increase in magnetization with an applied magnetic field and lose their magnetism when the field is removed. Neither hysteretic nor . This property allows efficient washing steps, low background and good reproducibility.
One use of paramagnetic Microspheres as large as 1mm in diameter to simulate salmon eggs, Scientists are able to place them in a natural habitat, observe how they move with the water currents and then use their magnetic properties to clean them up.

Fig. 3. PARAMAGNETIC MICROSPHERE
2) Different Form Of Polymeric Microspheres
2.1) Albumin Microspheres:-
The albumin is a widely distributed natural protein. The particulate or the colloidal form of albumin is considered as the potential carrier of drug for either there sites specific localization or their local application into anatomical discrete sites. Albumin microspheres loaded with anticancer drug such as misogynic-C were found to be more effective than the drug alone. Burger et al., 1985 observed that cisplatin- loaded microspheres are 10 times more potent in targeting the drug to the patient with hyper vascular liver carcinoma.
2.2) Gelatin Microspheres:-
It is a biodegradable polymer obtained from the partial hydrolysis of the collagen derived from the skin, connective tissue & bones of animals. The acid treated collagen is called type-A & the alkali treated is referred as type B.Gelatin microspheres.
The gelatin microspheres being susceptible for the macrophages recognition can be used as carrier for the antigens. The antigens from microspheres are released within the macrophages upon their degradation leading to enhanced production of antigen specific antibody
NOW YOU CAN ALSO PUBLISH YOUR ARTICLE ONLINE.
SUBMIT YOUR ARTICLE/PROJECT AT articles@pharmatutor.org
Subscribe to PharmaTutor Alerts by Email
FIND OUT MORE ARTICLES AT OUR DATABASE
3) Method Of Preperation
3.1) Polymerization techniques
The polymerization techniques conventionally used for the preparation of the micro spheres are mainly classified as:
3.1.1) Normal polymerization:- The two processes are carried out in a liquid phase. Normal polymerization proceeds and carried out using different technique as bulk suspension precipitation, emulsion and micelle polymerization process. In bulk polymerization, a monomer or a mixture of monomer along with the initiator is usually heated to initiate the polymerization and carry out the process. One catalyst or the initiator is added to the reaction mixture to facilitate or accelerate the rate of the reaction. The polymer so obtained may be molded or fragmented as micro spheres. For loading of drug, adsorptive drug loading or adding drug during the process of polymerization may be opted.
3.1.2) Interfacial polymerization:-
Interfacial polymerization essentially proceeds involving reaction of various monomer at the interface between the two immiscible liquid phased to form a film of polymer that essentially envelops the dispersed phase. In this technique two reacting monomers are employed, one of which is dissolved in the continuous phase while the other being dispersed in the continuous phase. The contininuous phase is generally aqueous in nature through which the second monomer is emulsified. The monomers present in either phase diffuse rapidly and polymerize rapidly at the interface.
Material used in the preparation of microspheres :-
1. Synthetic polymer
2. Non –biodegradable.
3. PMMA
4. Acrolein
5. Glycidyl methacrylate
6. Epoxy polymers
Biodegradable :-
Lactides and glycosides and these copolymers
Poly-alkyl cyano acrylates, poly-anhydrides
Natural materials :-
* Protein
* Gelatin
* Collagen
* Carbohydrates
* Agarose
* Carrageenan
* Chitosan
* Chemically modified carbohydrates
* DEAE cellulose
* Poly (acryl) dextran
* Poly (acryl) starch
4) Route of Administration
Micro spheres can be used for the delivery of drugs via different routes. Route of administration is selected depending on the drug properties, disease state being treated and the condition of the patient. Desirable properties of the microspheres used for the delivery will also change depending on the route of administration.
4.1) Oral Delivery:-
Oral delivery is the simplest way of drug administration. In oral drug delivery, the microspheres have to pass through frequently changing environments in the GI tract. There is also patent variation in GI content, so much emptying time and peristaltic activity. Although constrains of the oral route are numbers, on the whole, it less potential danger than the pretrial route. The relatively brief transit time of about 12 h through the GI tract limits the duration of action that can be expected via the oral route. Recently, it has been reported that microspheres of less than 10 un in size are taken up by the payer’s patches and may increase the retention time in the stomach. Eldrige el al. (1990) found that oral administration of poly-lactide co-glycodine microspheres containing staphylococcal enter toxin B is effective in including disseminated muccal Iga antibody response.
4.2) Parentral delivery:-
Most of the micro spheres based controlled delivery system are developed was the aim of using them for parental administration. Drug released is completely absorbed in this case. Micro spheres used for parental delivery should be sterile and should be dispersible in a suitable vehicle for injection hydrophilic micro spheres have the potential advantage of aqueous dispensability surfactants in small concentrations are often necessary for reconstituting hydrophobic particles for injection is aqueous vehicles which are reported to case adverse tissue reactions and affect the incorporated drug.
5) Mechanism of drug release:-
Theoretically, the release of drug from biodegradable micro spheres can he classified into four different categories. But actual, the mechanism is more complex and interplay of different mechanism may operate.
NOW YOU CAN ALSO PUBLISH YOUR ARTICLE ONLINE.
SUBMIT YOUR ARTICLE/PROJECT AT articles@pharmatutor.org
Subscribe to PharmaTutor Alerts by Email
FIND OUT MORE ARTICLES AT OUR DATABASE
5.1) For biodegradable: -
5.1.1) Degradation controlled monolith system:-
In degradation controlled monolithic microspheres system, the drug is dissolved in the matrix is in degradation controlled monolithic microspheres system, the dissolved and is released only on degradation of the matrix. The diffusion of the drug is slow compared with the degradation of the matrix. When degradation as by homogeneous bulk mechanism, drug release is show initially and increase rapidly when repaid bulk degradation starts. Drug release from such type of device in independent of the geometry of the device if the degradation is by homogeneous mechanism, degradation is confined to the surface. Hence rate of release is affected by the geometry of the device.
5.1.2) Diffusion controlled monolith system:-
Here the active is released by diffusion prior to or concurrent with the degradation of the polymer matrix. Degeneration of the polymer matrix affects the rate of release and to be taker into account. Rate of release also depends on whether the polymer degrades by homogeneous or heterogeneous mechanism.
5.1.3) Erodable polyagent system:-
In this case the active agent is chemically attach to matrix & the rate of biodegradation of matrix is slow compared to the rate of hydrolysis of drug-polymer bond. Assuming that the rate of diffusion of active agent from the matrix to the surrounding is rapid, the rate limiting step is the rate of cleavage of bond attaching drug to polymer matrix. This type of delivery is obtained in the release of norethindrone-17-chlorofirmate which is then attached to the –OH group of polymer. In vitro studies in rats using labeled drug polymer conjugate showed that a fairly constant release is obtained during the time of observation which was 5 months
5.2) Utilization of Microspheres in Body
Microparticulate carrier system can be administered through different routes such as i.v,ocular,i.m,oral,intra arterial.etc.Each routes has it’s own biological significance, limitation & pharmaceutical feasibility. The micro particles are intended to be administration through differents routes to achieve desired activity of either sustained action or targeting or both.Throgh different routes different mechanisms of uptake,transport & fate of translocated particles have been proposed.
Biodegradable microparticulate carriers are of interest for oral delivery of drugs to improve bioavailability, to enhance drug absorption,to target particular organ 7 to reduce toxicity to improve gastric tolerance of gastric irritant to stomach & as a carrier for antigen. The polystyrene microspheres administered orally are reported to be taken up by Peyer’s Patch. They are subsequently translocated to discrete anatomical compartments such as mecentric lymph vessels,lymh nodes & to a lesser extent in liver & spleen. The particulates matters gain entry into follicle associated epithelium through Peyer`s patches.
After the uptake of particulate carriers via different mechanism their fate become more important. Some uptake mechanism avoids the lysosomal system of the enterocytes.The particles following uptake by enterocytes are transported to the mecentric lymph, followed by systemic circulation & subsecuently phagocyosized by the Kupffer cells of liver.However,after uptake by enterocytes,some particulate carriers may be taken up into vacuoles & discharged back into gut lumen.
Microsperes can also be designed for the controlled release to the gastrointestinal tract. The release of drug contents depends on the size of micro particles & the drug content within microspheres.The release of the drug could be regulated by selecting an appropriate hydrophilic/lipophilic balance of the matrix such as in case of matrix of polyglycerol,ester of fatty acids.Microparticles of mucoadhesives polymers get attached to the mucous layer in GIT & hence, prolong the gastric residence time & functionally offer a sustained release. The microspheres of particle size less then 0.87 µm are taken to the general circulation. The fluid environment of the GIT can affect the number & rate of particles translocation.
6) Application of Microspheres
6.1) In enteric release dosage form.
Drugs which are irritant to the stomach & other side effects like aspirin, pancrelipase & erythromycin, salbutamol sulphate can be incorporated in microspheres for their selective release in intestine.
6.2) To protect reactive materials against environment.
It is useful for drugs vitamins. Aspirin which aresensitiveto oxygen & water.
6.3) To mask bitter of unpleasant taste of the drug
E.g. for drugs such as quinidine, nitrofurantion, paracitamol prednisolone, metronidazole, fish oils, sulpha drugs, clofibrate, alkaloids & salts.
6.4) For drug targeting.
E.g. casein & gelatin microspheres containing Adriamycin & iterferons respectively were magnetically delivered to tumour site. Albumin microspheres used for anti-inflammatory agents for directing against knee joints.
6.5) As a topical drug delivery system.
E.g.Microspheres of benzoyl peroxide for their bactericiday activity against acne.
6.6) As an antidote in the poisoning of heavy metals.
E.g Polymercaptal microspheres as an antidote against mercury poisoning.
6.7) As antigen carrier.
E.g. & PLGA microspheres of varying composition have used to improve the ability of the antigens to provoke a mucosal immune response.
6.8) To reduce gastric irritation.
Hard gelatin capsule containing microspheres liberate in stomach & spread in the overall GIT, thus ensuring more reproducible drug absorption with less local irritation
NOW YOU CAN ALSO PUBLISH YOUR ARTICLE ONLINE.
SUBMIT YOUR ARTICLE/PROJECT AT articles@pharmatutor.org
Subscribe to PharmaTutor Alerts by Email
FIND OUT MORE ARTICLES AT OUR DATABASE
7) EVALUATION OF MICROSPHERE
7.1) Size & shape of microspheres
The size of microspheres was determined using microscope (Olympus NWF 10x, Educational scientific Stores, India) fitted with an occular micrometer & stage micrometer.Scaning electron microscopy (SEM)
7.2) Flow properties
The Flow properties of microspheres were characterized in terms of angle of repose, Carr index & hausner ratio (θ), the microsphere were poured through the walls of a funnel, which was fixed at a position such that its lower tips was at a height of exectly 2.0 cm above hard surface. The microspheres were poured till the time when upper tip of pile surface touched the lower tip of funnel. The tan^(-1)0f the height of the pile/radius of its base gave the angle of repose
7.3) In vitro buoyancy
Microspheres (300mg) were spread over the surface of USPXXIV dissolution apparatus type II filled with 900ml of 0.1 N HCL containing 0.02% tween 80.The medium was agitated with a paddle rotating at 100 rpm for 12hr.The floating microspheres & settled portions were removed separately. The microspheres were dried & weighed. Buoyancy % was calculated as the ratio of the mass of the microspheres that remained floating & the total mass of the microspheres.
7.4) In corporation efficiency (IE)
To determine incorporation efficiency floating microspheres were dissolving in a minimal amount of dichloromethane & the drug was extracted into a suitable aqueous media(0.1N HCL)by evaporating dichloromethane. The solution was filtered through 0.45 m membrane, diluted suitably & analyzed for drug content sprectrophotometrically at 278 nm using 0.1 N HCL as blank.
7.5) In vitro drug release studies
The drug was studied using a USP24 dissolution apparatus type I(veego Scientific, Mumbai) at 100rpm in 0.1N HCL as dissolution medium(900ml) maintained at 37±1°c.A sample(ml)of the solution was withdrawn from the dissolution apparatus hourly & the samples were replaced with fresh dissolution medium. The sample were filtered through a 0.45 µ membrane filter & diluted to a suitable concentration with 0.1 N HCL.Absorbance of these solutions was measured at 278 nm using a Thermospectronic -1 UV/Visdouble beam spectrophotometer. Cumulative % drug release was calculated using an equation obtained from a standard curve.
Conclusion
Microspheres offer an excellent solution to creating precise pore sizes in ceramics at reasonable prices. Polyethylene microspheres offer the added benefit of minimal residue after firing, and the availability in wide size ranges from a few micron up to 1000um (1mm). Highly spherical microspheres have the added benefit of creating strong pores without any stress riserst Floating microspheres of verapamil HCL were prepared by a solvent evaporation method.The nature of polymer influenced the physical characteristics as well as floating behaviour of the microspheres In vitro buoyancy & in vivo studies conformed the exellent floating properties of cellulose acetate microspheres.The drug release fromsufficiently sustained & non-fickian transport of drug from floaing microspheres aws conformed.Hence the floating microspheres of verapamil HCL prepared with cellulose acetate,may providee a convenient dosage form for achieving best performance regarding flow,release & flow properties.Further,their potential to improve verapamil HCL bioavailability in humans need to be investigated in further studies.
Bibliography:
- N.K. jain (2002), Controlled & Novel drug delivery system. 1st edition, p. 202-205
- S.P. khar & B.P. vyas (2001) Targeted & controlled drug delivery system.1st edition, p. 180-205
- Gohel M.C.,Sheth M.N.,Patel M.M.,Jani G.K., & Patel H., (1994) Indian J.Pharma sci.(56), p.210
- Goodfriend T.L.,Levine L. & Fasman G.D.(1964) Sci.(144),p.1344.
- Gopferich A., Alonso M.J. & Langer R.(1994) Pharma Res. (11), p.1568.
- Hashida M.,Muranishi S.,Sezaki H.,Tangigawa Nosotomura K. & Hikasa Y.(1979).Int. J.Pharma(2), p.145.
- Harmann J.B.,Kelly R.J. & Higgins G.A.(1970).Arch.Surg.(100), p.486.
- Ikda Y. & Tabata Y.(1982). J.Bioact.Compt.Polym.(1), p.31.
- Illum L., Davis S.S.,Muller R.H., Mak E. & West P (1987).Life. Sci. (40), p.367.
- Illum l., Jones P.D.E.,Kreuter J., Bardwin P.W. & Davis S.S.(1983).Int J. pharma. p. 65.
- Jalil R. & Nixon J.R. (1990). J.Microencapsulation (7), p.297.
- Jani P. Halbert G.W.,Langridge J. Florence A.T. (1990).J. Pharmacol (42), p.821.
- Kandjia J., Anderson M.J.D., & Muller Ruchholtz W.(1981).J. Cancer.Res.Clin.Oncol. P.101-165.
- Kante B., Couvreur P.,Dobosis Krack G., De Meester C.,Guoit P.,Roland M.,Mercier M. & Speisen P.(1982). J. Pharma Sci.(71), p. 786.
- Kasab A.c.,Xu K.,Denkbas E.B.,Dou Y.,Zhao S. & Piskin e.(1997).J.Biomat, Sic. Polymer edition vol 8 ,12 , p.947.
- Kikuchi A.,Kawabuchi M.,Sugihara M.,Sakurai Y., & Okano T.(1996).Procced Int. Symp.Rel.Bioact.Mater.(23), p.737.
- Gurny R.,Boyle T. & Ibrahim H.(1985) J. Control.Rel. (2), p.353.
- Griffin F.M.,Griffin J.A.,Lejder J.E. & Silvertain S.C.(1975) J.Exp.Med.(142), p.1263.
- Kabnov & Zezin A. B., (1982).Sol.Sci.Rev.Sec.Biochem Rev.(4), p.207.
- Speisen P. (1982). J. Pharma Sci. (71), p.786.
- Koff US Patent (March 2, 1963)3, 80, p.292.
- L.I. Giannola et al., (2005), Int. J. Immunopathol. Pharmacol., (18), p. 21–31
- N. Langoth, J. Kalbe and A. Bernkop-Schnürch, (2005), Int. J. Pharm., (296), p.103–111
- Y. Sudhakar, K. Kuotsu and A.K. Bandyopadhyay, (2006), J. Control.Release, (114), p.15–40
- L.I. Giannola et al., (2007), Eur. J. Pharm. Biopharm., (67), p.425–433
- A. Portero et al., (2007), Carbohydrate Polymers, (68), p.617–625
- I. Diaz del Consuelo et al., (2007), J. Control. Release, (122), p.135–140
NOW YOU CAN ALSO PUBLISH YOUR ARTICLE ONLINE.
SUBMIT YOUR ARTICLE/PROJECT AT articles@pharmatutor.org
Subscribe to PharmaTutor Alerts by Email
FIND OUT MORE ARTICLES AT OUR DATABASE

